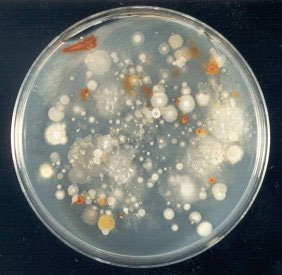
Культура почвенных бактерий. В действительности в лабораторных условиях можно культивировать только 1% всего разнообразия почвенной флоры. Фото с сайта www.rothamsted.ac.uk

Ученые из Великобритании на страницах журнала Science опубликовали результаты исследования пространственного масштаба, на котором удается отследить эволюционные преобразования в микромире. А немногим раньше аналогичное исследование размера экологической ниши простейших выполнили российские ученые. Масштаб и экологического, и эволюционного пространства для микроорганизмов оказался примерно одного порядка — не более нескольких сантиметров.
Ученые с зоологического факультета Оксфордского университета и из Центра экологии и гидрологии в Оксфорде на примере почвенных бактерий и бактериофагов исследовали отношения «хозяин—паразит». В основе исследования лежит очевидное положение, что степень вирулентности паразита служит мерилом адаптированности хозяина к присутствию паразита и паразита к защитной тактике хозяина. Если паразит легко заражает хозяина и гибель хозяина от инфекции велика, то это означает, что паразит хорошо адаптирован к защитным приемам хозяина, а хозяин, напротив, не смог выработать адекватные способы защиты. Если же гибель хозяина снижена, то можно утверждать, что хозяин приобрел в ходе эволюции эффективные меры защиты. В системе «хозяин—паразит» происходит безостановочное соревнование способов нападения и защиты. Поэтому по степени вирулентности бактериофагов ученые судили об адаптированности бактерий и бактериофагов и о том, кто выигрывает это смертельное соревнование.
Исследование было организовано таким образом, чтобы выявить различие в вирулентности бактериофагов по отношению к бактериям из разных точек опытной площадки. Вся площадка размером 25 × 25 см разделена была на участки по 5 кв. см, и из каждого участка брали пробу почвы (всего 25 проб). Из каждой пробы получали бактериальный посев и соответствующий раствор бактериофагов. Наиболее массовым видом почвенных проб были бактерии Stenotrophomonas sp., и этот вид оказался единственным чувствительным к выделенным бактериофагам. После этого посев бактерий из каждого участка сливали с суспензией бактериофагов из каждого участка и подсчитывали, насколько заразным окажется раствор бактериофагов. Так как на месте заражения происходит лизис (разрушение) клеток, то зараженные участки хорошо видны, и посчитать степень зараженности не так уж и сложно.
Выяснилось, что бактериофаги были на 9% более заразными для бактерий из «своего» участка, чем для любых других, и это различие статистически значимо. Расстояние между пробами (от 5 до 25 см) не влияло на степень вирулентности бактериофагов.
Этот результат позволил ученым сделать два важных вывода. Во-первых, почвенные бактериофаги быстрее вырабатывают способы инфицирования, чем бактерии находят способы защиты от своих паразитов. Иными словами, бактерии проигрывают своим паразитам гонку вооружений. Ученые объясняют это большей генетической пластичностью бактериофагов и их большим генетическим разнообразием по сравнению с бактериями. Во-вторых, плацдарм этой гонки вооружений оказывается не больше одного-двух квадратных сантиметров (таков размер лабораторной посуды для взятия проб). В противном случае степень вирулентности зависела бы от расстояния между пробами. Последний вывод удивителен еще и потому, что пробы почвы были взяты на заливном лугу, который хорошо дренируется. Так что теоретически бактериальная флора должна перемешиваться. Но видно, бактериофаги чрезвычайно быстро адаптируются к защитным приемам хозяина, и перемешивание не играет существенной роли в локальных обстановках, масштабы которых — один-два сантиметра.
Интересно, что недавно в Журнале общей биологии была опубликована статья о масштабировании экологических исследований микро- и макрообъектов: Д. В. Тихоненков, Ю. А. Мазей «Пространственная структура сообщества гетеротрофных жгутиконосцев сфагнового болота» (см. популярный синопсис этой статьи на «Элементах»). В статье российских авторов показано, что экологическое пространство мира микроорганизмов имеет сантиметровый масштаб. Уже на «опытных площадках» размером больше 10 сантиметров никаких микросообществ простейших (жгутиконосцев) не удается различить. А значит, размер их экологической ниши не может быть больше нескольких сантиметров. Так что величина пространства, где происходят микроэволюционные процессы, приводящие к экологическим и генетическим различиям, определяется несколькими сантиметрами.
Однако вполне возможно, что сантиметровый размер — это минимальная разрешающая способность экспериментального оборудования (пробирок, пипеток и т. д.), созданного представителем макромира — исследователем. Так что масштаб эволюционного плацдарма микромира может оказаться еще меньше.
Источник: Michiel Vos, Philip J. Birkett, Elizabeth Birch, Robert I. Griffiths, Angus Buckling. Local Adaptation of Bacteriophages to Their Bacterial Hosts in Soil // Science. 2009. V. 325. P. 833. DOI: 10.1126/science.1174173.
Елена Наймарк



